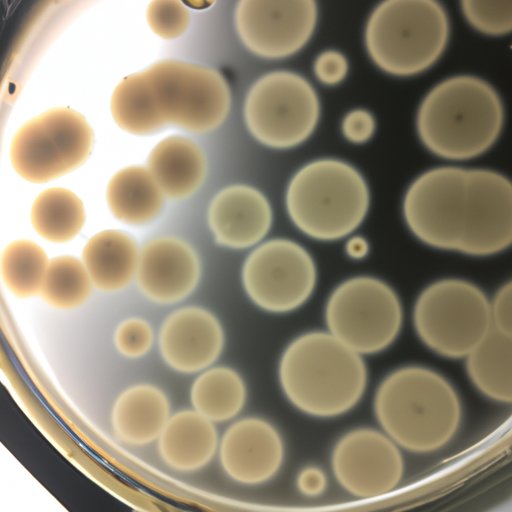

Introduction
Bacterial culture is a process that involves growing bacteria in a laboratory. It is used to study the growth of bacteria, identify unknown bacteria, and test the effectiveness of antibiotics. This article will explore what bacterial culture is, the different types and uses of bacterial cultures, how to create a bacterial culture, and how to identify one using microscopy techniques. It will also examine the role of antibiotics in bacterial culturing.
The Different Types of Bacterial Cultures and Their Uses
There are several different types of bacterial cultures that can be used for different purposes. The most common types are broth cultures and agar plates.
Broth Cultures
Broth cultures are liquid media that contain nutrients that allow bacteria to grow. They are often used to study the growth rate of bacteria, as well as to identify unknown bacteria. According to a 2017 study by the National Institutes of Health, “Broth culture is a valuable tool for the identification of bacteria and their antimicrobial susceptibility testing.”
Agar Plates
Agar plates are solid media that contain nutrients that allow bacteria to grow. They are often used to isolate and identify specific species of bacteria. According to an article published by the American Society for Microbiology, “Agar plates are used to isolate pure cultures of bacteria, fungi, or other microorganisms.”
Other Types of Bacterial Cultures
Other types of bacterial cultures include deep agar plates, pour plates, and spread plates. Deep agar plates are used to study the growth of bacteria in three-dimensional environments, while pour and spread plates are used to study the growth of bacteria on the surface of the medium.

Exploring the Benefits of Bacterial Culturing
Bacterial culturing has many benefits, from understanding the growth cycle of bacteria to enhancing the safety of food and other products. Here are some of the advantages of bacterial culturing:
Understanding the Growth Cycle of Bacteria
By studying the growth of bacteria in a laboratory setting, scientists can gain insight into the life cycle of bacteria and how they respond to different environmental conditions. This knowledge can then be used to develop more effective treatments for bacterial infections.
Enhancing the Safety of Food and Other Products
Bacterial culturing can be used to identify and eliminate bacteria that can cause food poisoning or other illnesses. Additionally, it can be used to ensure that products such as cosmetics, medications, and medical devices are free of potentially harmful bacteria.
Research Applications
Bacterial culturing is also used in research to study the effects of various substances on bacteria. This type of research can help scientists develop new antibiotics, vaccines, and other treatments for bacterial infections.
The Step-by-Step Process of Creating a Bacterial Culture
Creating a bacterial culture involves several steps, including preparing the culture medium, transferring the cells to the medium, incubating the culture, and examining the results. Here is an overview of the steps involved in creating a bacterial culture:
Preparing the Culture Medium
The first step in creating a bacterial culture is to prepare the culture medium. This involves mixing together the necessary ingredients to create a nutrient-rich environment that will allow the bacteria to grow. These ingredients may include water, salts, sugars, vitamins, and other nutrients.
Transferring the Cells to the Medium
Once the culture medium has been prepared, the next step is to transfer the bacterial cells to the medium. This is usually done by pipetting a small amount of the cells onto the medium. The cells will then begin to multiply and form colonies.
Incubating the Culture
After the cells have been transferred to the medium, the next step is to incubate the culture. This involves placing the culture in an incubator at the optimal temperature and humidity for the bacteria to grow. The incubation period typically lasts several days.
Examining the Results
Once the incubation period is complete, the next step is to examine the results. This involves looking at the colonies to identify the type of bacteria present and counting the number of colonies to determine the relative concentration of bacteria. This information can then be used to identify the bacteria and assess its growth rate.

Understanding the Role of Antibiotics in Bacterial Culturing
Antibiotics are commonly used in bacterial culturing to prevent the growth of unwanted bacteria. Here is an overview of how antibiotics work and the importance of understanding antibiotic resistance:
How Antibiotics Work
Antibiotics work by killing or inhibiting the growth of bacteria. They do this by targeting specific molecules or processes that are essential for the survival of the bacteria. For example, some antibiotics target the cell wall of the bacteria, while others target the proteins that the bacteria need to survive.
Selective vs. Non-selective Antibiotics
Antibiotics can be either selective or non-selective. Selective antibiotics are designed to target specific types of bacteria, while non-selective antibiotics will target all types of bacteria. When using antibiotics in bacterial culturing, it is important to choose the right type of antibiotic to ensure that only the desired bacteria are killed or inhibited.
The Importance of Understanding Antibiotic Resistance
It is also important to understand the concept of antibiotic resistance, which is when bacteria become resistant to the effects of antibiotics. This can occur when bacteria are repeatedly exposed to the same type of antibiotic and develop mutations that allow them to survive despite the presence of the antibiotic. To prevent the development of antibiotic resistance, it is important to use a variety of antibiotics and rotate between them.

How to Identify Bacterial Cultures Using Microscopy Techniques
Once a bacterial culture has been created, the next step is to identify the bacteria using microscopy techniques. Here is an overview of how to differentiate between types of bacteria and identify specific characteristics:
Differentiating Between Types of Bacteria
One way to differentiate between types of bacteria is to look at the shape and size of the cells. For example, rod-shaped bacteria are called bacilli, while spherical bacteria are called cocci. Additionally, bacteria can be classified based on the type of flagella they have, if any.
Using Optical Microscopy to Identify Specific Characteristics
Optical microscopy can also be used to identify specific characteristics of bacteria, such as the presence of capsules or spores. Additionally, optical microscopy can be used to observe the arrangement of the cells in the culture and to measure the size of the cells.
Utilizing Fluorescence Microscopy
Fluorescence microscopy can also be used to identify bacteria. This technique uses fluorescent dyes to make certain parts of the cells glow, allowing scientists to easily identify specific characteristics. Additionally, fluorescence microscopy can be used to measure the concentration of bacteria in the culture.
Conclusion
This article has explored what bacterial culture is, the different types and uses of bacterial cultures, how to create a bacterial culture, and how to identify one using microscopy techniques. It has also examined the role of antibiotics in bacterial culturing. Bacterial culturing is an important tool for identifying and eliminating dangerous bacteria, as well as for conducting research into the effects of various substances on bacteria. By understanding the different types of bacterial cultures and how to create and identify them, scientists can continue to make advancements in the field of bacteriology.
(Note: Is this article not meeting your expectations? Do you have knowledge or insights to share? Unlock new opportunities and expand your reach by joining our authors team. Click Registration to join us and share your expertise with our readers.)